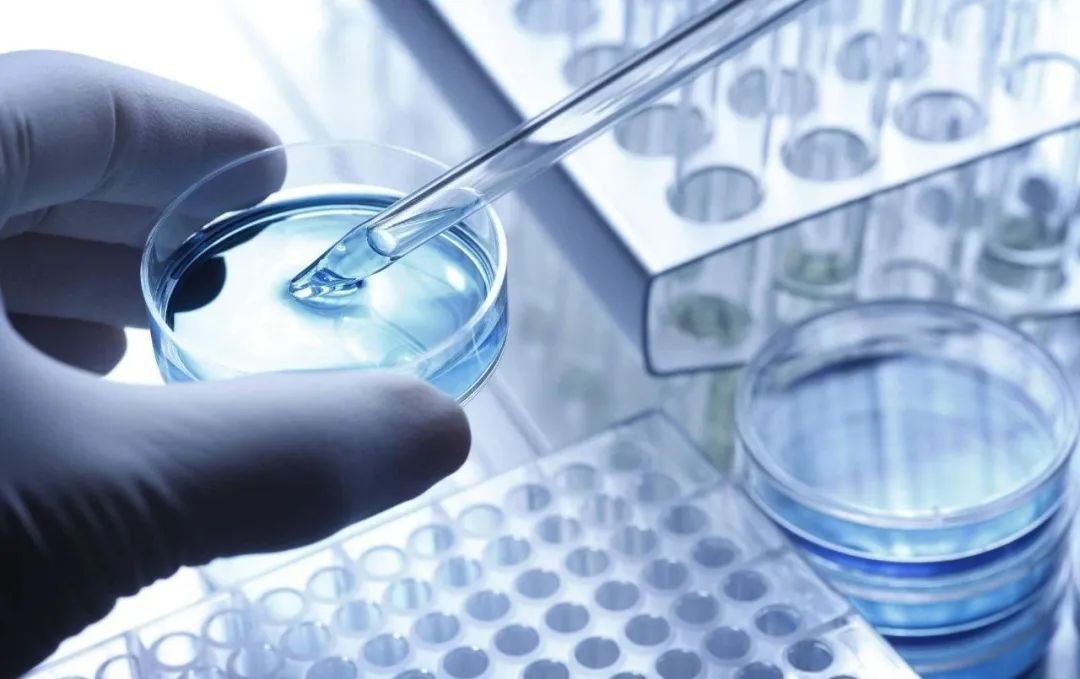

来源:圆方你怎么看啊
微信ID:yflooklook
7月4日,上海合作组织成员国元首理事会在新德里以视频方式举行。成员国领导人签署并发表新德里宣言。
最近一段时间,大家伙的注意力似乎都放到了中美会谈和法国暴乱上,大家对于上合组织这个会议似乎关注不是很多。
其实站在更长周期,更广维度来看,中美关系固然重要,但是上合组织所团结的这一批资源国和生产国在未来世界秩序中的位置,才是这百年未有之大变局的关键因素。
今天我们一起聊聊:
来自新德里宣言的隐忧
01
这次上合会议,从成员的角度有了变化,伊朗成为成员国,同时也签署白俄罗斯加入本组织义务的备忘录。
其中伊朗在2005年成为上合组织的观察员国,在2021年的杜尚别峰会上获得了成员资格,并在2022年的撒马尔罕峰会上签署加入上合组织义务备忘录。在履行相应的法律程序后,在今年的峰会上正式加入上合组织。
客观来说,伊朗加入上合组织,这当然对于上合组织的影响力扩大是一个证明。包括两伊和解,以及阿根廷首次用人民币归还外债,这都说明中国的影响力在不断扩大。
同时我们也要看到,现在这套合纵连横的打法,的确是二战后美国建立国际秩序的方案,通过石油美元以及一系列的国际组织,把世界秩序牢牢地掌控在自己手中。但是随着时代发展,技术进步,这种打法是否能够在新的“游戏规则”下,掌控世界秩序,或许每个人会得出不一样的答案。而这一点。从这次上合组织“新德里宣言”中就可以看出。在这次宣言中,重申了诸如“坚决打击恐怖主义、分裂主义和极端主义”;“个别国家或国家集团单方面不受限制地加强全球反导系统将危害国际安全与稳定,成员国认为,以牺牲他国安全为代价谋求自身安全不可接受”;“继续完善全球经济治理体系十分重要,将继续维护和巩固以世界贸易组织的原则和规则为基础的开放、透明、公正、包容、非歧视的多边贸易体制”等内容,但是更为关键的的是“新德里宣言”开篇所提到的这一段:“宣言指出,当今世界正经历前所未有的转型变革,进入技术大发展的新时期,需提升全球体系有效性。”什么叫做“进入技术大发展的新时期,需提升全球体系有效性”?这里面,我们需要先认识到进入了什么技术大发展。根据个人的判断,主要是三个方面的突破:一、新型能源
二、人工智能
我们一个一个分析,先看新型能源,新型能源不光是新能源,不光是风光这样新能源生产,更包括和能源生产相匹配的配置,储能,交易等一系列配套系统。中国的新能源生产技术力,生产能力压全球,这个可能是最早推动新能源环保议题的欧美没有想到的。中国通过体制优势和产业政策,在新能源竞争中获得了一系列优势,但是中国的能源配置却落后于产能增长,这也带来了巨大的浪费和无效配给,也无法真正激活全社会,甚至每个家庭参与电力市场的动力。这是对国内,往国外看,比如上合组织的成员国,基本上都是“传统能源”的生产国和需求国,而且从技术端到市场端,这些国家也很难独立走进新能源的世界。再看人工智能,之前写了很多篇论述人工智能的文章,大家可以往前翻一翻。可以确定的是,这一轮人工智能大概会通过3-5年的时间,基本取代80%的白领工作。这个取代并不是公司突然用人工智能替代人工了,而是基于人工智能构建的公司,从待遇和竞争力上,远远超越不是基于人工智能构建的公司,从而完成市场份额的转换。类比的话,或许有点像新媒体替代传统媒体报纸这样的逻辑。而在这个角度来看,中国或许是唯一有数据,也有能力跟上人工智能进展的国家,其他的国家,比如上合组织成员国其他的国家,很大概率不太会跟上这一波浪潮。最后是生物医药,在新冠时期,欧美付出了很大的代价,但是也换来了生物技术的大幅进步。(特殊时期,特殊政策,推动了新药研发批准取得了豁免)而这些成果,是全世界有钱人都心心念念需要的。其他的诸如脑机接口,人造子宫等技术,或许也已经在人类整体“进化”的路上。这一点中国怎么样?哎。这个说起来就都是泪,这一点中国的差距还挺大的。而且随着中国对于医药采购端越来越严格的控制,大概率新药,新器械,新设备研发的逻辑也在发生变化。所以,可以看到“上合组织”的成员国大部分是第二次工业革命技术扩散的受益者,不管是作为资源国还是制造国。但是随着技术加速演变。如果以美国为代表的一系列国家,基于这次技术大爆发的第三次技术革命,通过新能源完成了能源自给自足,通过人工智能完成了生产环节的全面自动化(黑灯工厂),完成了大部分工业品的自给自足。同时再通过独步天下的“生物医药“”和“虚拟现实”技术去赚所有有钱人“肉体上”和“精神上”的钱。那么得益于第二次工业革命技术扩散的这些资源国和制造国,未来又将如何自处呢?
比如全球化之前的时代,美国的的工会还可以把工人组织起来与大的工厂谈判,但是经济全球化之后,这些工厂把生产全部搬迁到了其他国家,那么这个时候工会和工人也就没有了谈判的筹码,也就慢慢成为了被“被遗忘的美国人”。不过中国也不要担心,一方面我们处在二次和三次技术革命的中间,凭借“科技自立自强”也不是没有突破的希望,另一方面如果这种不平衡持续加剧,那么世界这些“被遗忘的国家”,未必不会像美国那些“被遗忘的美国人”那样,选出一个世界的特朗普。听党话,跟党走
学习时间
世界各国要坚持真正的多边主义,坚持拆墙而不筑墙、开放而不隔绝、融合而不脱钩,推动构建开放型世界经济,推动经济全球化朝着更加开放、包容、普惠、平衡、共赢的方向发展,让世界经济活力充分迸发出来。
——2022年1月17日出席2022年世界经济论坛视频会议时发表的演讲